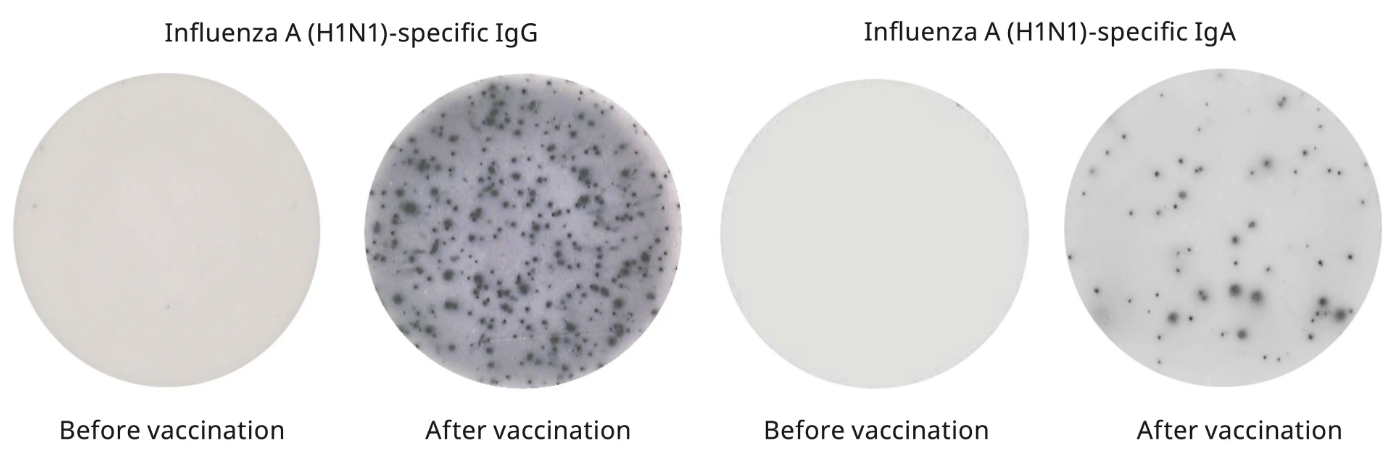
图2 图2

16 年
手机商铺
公司新闻/正文
373 人阅读发布时间:2024-11-14 16:04
ELISpot用于定量分泌目标蛋白质的细胞数。常在免疫学研究中用于T细胞和B细胞的分析检测。例如ELISpot可用于研究抗原特异性免疫反应和区分活化T细胞的亚群,广泛应用于传染病、癌症、过敏和自身免疫性疾病的研究中。在疫苗研究中,可以通过ELISpot分析IFN-γ分泌情况,评估T细胞反应的能力,从而来评价疫苗效力。

图1.外周血单核细胞(PBMCs)在无刺激或CD3抗体、植物血凝素(PHA)和纯化蛋白衍生物(PPD)存在的情况下过夜孵育后分泌IFN-γ的情况。
ELISpot是少数几种在分泌时直接测量B细胞分泌免疫球蛋白的方法之一,可用于评估抗体分泌细胞(antibody-secreting cells,ASCs)。由于其敏感性,该方法能够鉴定识别特异抗原的ASC。其次,可以评估刺激后活化的循环抗原特异性记忆B细胞(circulating antigen-specific memory B cells)。因此,ELISpot常用于评估由感染或疫苗接种引起的B细胞反应。
图2.在接种流感疫苗之前和之后收集PBMCs,并通过ELISpot分析甲型H1N1流感特异性IgG和IgA的分泌。
想要ELISpot做得漂亮,好的细胞样本必不可少。Mabtech实验室拥有丰富的ELISpot检测经验,下面是Mabtech总结的细胞样本准备小贴士。
1.选择合适的细胞培养基
合适的细胞培养基对于维持细胞良好的状态非常重要。对于大多数细胞,Mabtech建议使用含有L-glutamine和10% fetal calf serum(FCS)的RPMI 1640细胞培养基。Mabtech通常会在培养基中添加HEPES以保持细胞培养基的pH值,还会添加抗生素以降低污染的风险。对于有些细胞RPMI 1640培养基可能不是最佳的选择,建议进行预实验找到最合适的细胞培养基。
Mabtech建议将FCS作为血清源。好的FCS不仅能支持细胞培养,即其本身不引起细胞活化或者目标蛋白质分泌,也能保证染色时的低背景。Mabtech建议不要使用同源血清(例如,检测人细胞样本不要使用人血清培养细胞),因为同源血清可能含有目标分析物和嗜异性抗体(heterophilic antibodies),会引起背景染色。如果实验中不能使用FCS,可使用含有蛋白质成分明确的无血清培养基作为血清的替代品。在Mabtech测试过的所有无血清培养基中,AIM-V最适合ELISpot实验。
Mabtech常用培养基配方:

2.选择合适的细胞密度
可以采用自动化细胞计数仪器或者显微镜下台盼蓝染色计数测定细胞密度和活力情况。只有活细胞才能够分泌目标蛋白,尽可能排除死亡细胞和凋亡细胞。
如果不确定每孔加入的细胞密度,Mabtech建议首先从每孔250,000个细胞开始:每个孔中的细胞数量必须与细胞类型和预期分泌细胞的数量相适应:预期分泌目标检测物的细胞越少,那么每个孔中所加的细胞数量越多。举个例子,如果预期分泌目标检测物的细胞是10000个细胞里面1个细胞分泌,那么每个孔就需要大约25万个细胞。相反,预期分泌目标检测物的细胞越多,例如100个细胞中就有1个细胞分泌,那么每孔接种5万个细胞就足够了。总体来说,如果检测抗原特异性反应需要较高的细胞数量,例如每孔250,000个细胞,使用抗体或者促进细胞有丝分裂的阳性对照刺激细胞例如PHA,每孔50,000个细胞是足够的。
形成斑点的数量并不总是和细胞数量相关,有时也与细胞之间的相互接触有关系。细胞之间需要适当接触,才能正常生长与增殖,所以要保证有适当数量的细胞来确保细胞间的接触。例如当分析抗原特异性 PBMC样本中的T细胞时,每孔总细胞数量不应少于200,000个。
3.优化细胞刺激方式
对于需要较长时间才分泌的目标分析物,可以采用预刺激细胞的方式。例如刺激记忆B细胞,可以在细胞培养管或瓶中使用R848 + IL-2刺激72h来促进分泌免疫球蛋白的浆细胞分化。如果选择预刺激,细胞必须在加入ELISpot板前进行清洗,以避免背景染色。
4.设置适当的对照
以下是Mabtech建议的对照设置

温馨提示:本文中的实验步骤仅供参考,实验时请按照产品说明书操作。
更多产品详情请咨询Mabtech中国授权代理-欣博盛生物
全国服务热线: 4006-800-892 邮箱: market@neobioscience.com
深圳: 0755-26755892 北京: 010-88594029 上海: 021-34613729
广州:020-87615159 香港: 852-69410778
代理品牌网站: www.neobioscience.com
自主品牌网站: www.neobioscience.net